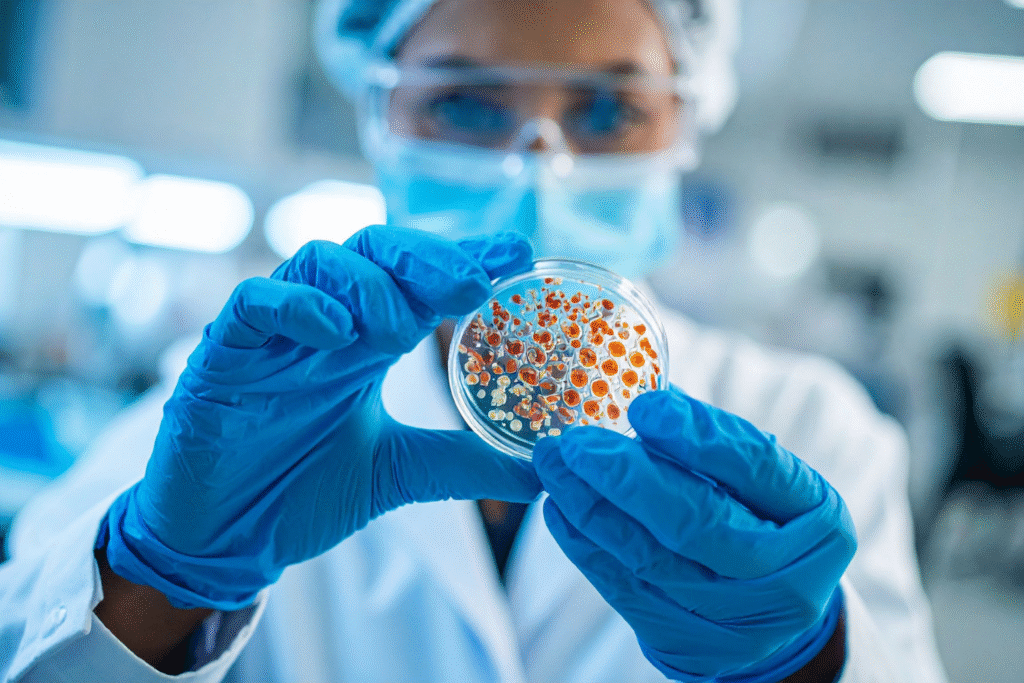

The Ice Is Not as Silent as It Looks

For thousands of years, the Arctic has acted like a vault no one could open. Beneath its frozen ground lie layers of soil untouched by sunlight, sealed away from air, pressure, and time itself. But that seal is weakening. As temperatures climb and ancient permafrost softens, scientists are beginning to glimpse what has been preserved below the surface. It is not just bones or plant remains. It is something far smaller, far older, and far less understood. What is emerging from the thaw is forcing researchers to reconsider what the frozen Earth has been holding in suspension all along.
1. Ancient viruses have been revived after 30,000 years in ice.

Researchers successfully reanimated Pithovirus sibericum from Siberian permafrost that had been frozen for approximately 30,000 years, demonstrating that ancient viruses can remain infectious across geological time. The revived virus only infected amoebae, but its endurance stunned scientists studying permafrost microbiology. The experiment confirmed that deep freeze conditions can preserve viral DNA far longer than previously believed, allowing full replication once warmth returns. This finding was published by Nature, which documented the first case of an ancient virus retaining infectivity after tens of millennia underground, altering how scientists view microbial survival in frozen worlds.
2. Thawing permafrost is now exposing these viral relics to modern ecosystems.

Across Siberia, Alaska, and northern Canada, vast sections of permafrost are beginning to soften, revealing layers of ancient organic matter and with it, microscopic remnants of long-frozen viruses. Researchers warn that as ice melts, these biological time capsules can mix with meltwater and surface soil, increasing the chances of contact with modern hosts. That concern is not speculative but rooted in field observations showing permafrost layers actively releasing microbial material. This scenario was described by scientists interviewed in The Guardian, which reported that “zombie viruses” preserved for millennia could become reactivated as global temperatures rise.
3. Recently revived viruses show surprising diversity and resilience.

Scientists studying Siberian permafrost have now identified at least thirteen previously unknown viruses capable of infecting single-celled hosts, proving that ancient viral diversity was far greater than expected. These findings came from controlled lab experiments where frozen samples were thawed and safely tested using amoebae as host cells. The results showed that even after 48,500 years, genetic integrity and replication capacity can remain intact under the right conditions. As documented in the Frontiers in Microbiology study led by Jean-Marie Alempic, these revived viruses expand the known evolutionary tree and highlight just how durable ancient life can be under permafrost preservation.
4. The Arctic holds far more frozen life than previously assumed.

Permafrost covers about one-quarter of the Northern Hemisphere, storing not only viruses but bacteria, spores, and DNA from long-extinct species. As these ancient layers thaw, they release remnants of life that once thrived during glacial cycles. Some of these organisms may remain inert, while others could find new ecological niches. The frozen Earth, it seems, has not been silent, it has simply been waiting for warmth to return.
5. Giant viruses point to an unknown biological legacy beneath the ice.

Many of the revived viruses belong to a category called “giant viruses,” so large they are visible under a standard light microscope. Their complex genomes contain hundreds of genes, including some never seen in modern strains. This complexity suggests that ancient viral evolution may have followed very different pathways. Each revived specimen acts like a living fossil, hinting at an entire microbial biosphere that thrived in prehistoric climates and could still inform our understanding of how viruses evolved alongside early life.
6. Climate change is accelerating the exposure of these frozen archives.

Average Arctic temperatures are now climbing faster than global averages, leading to rapid degradation of permafrost layers. As this frozen ground thaws, trapped organic matter decomposes and microbial life, including ancient viruses, can re-enter circulation. Scientists monitoring Arctic melt zones say this release is not an isolated event but a trend likely to intensify with each decade. It’s an unfolding experiment conducted by the planet itself, with unpredictable biological outcomes.
7. The ecological impact may outweigh the direct threat to humans.

While none of the revived viruses so far infect humans, their interactions with modern microbes could still reshape ecosystems. Ancient viruses could infect bacteria or protists that play crucial roles in nutrient cycling, shifting entire food webs in subtle but long-lasting ways. Understanding these effects requires tracking microbial communities in permafrost melt zones, an effort already underway across Siberia, Scandinavia, and northern Canada.
8. Researchers are racing to map what’s hidden in the ice.

Using advanced sequencing, scientists are cataloging the genetic content of ancient soil layers before they disappear. The goal is to understand what types of viruses and microbes exist, how they evolved, and whether they could survive exposure. This massive mapping effort reflects a simple reality: what we don’t yet know about the frozen biosphere may have consequences long after it melts.
9. Reviving these viruses raises new ethical and safety questions.

Even with strict laboratory containment, the process of reactivating ancient viruses carries risk. Scientists are debating how far such experiments should go, balancing the pursuit of knowledge with the potential for accidental release. The field of “paleovirology” now faces the same scrutiny that modern pathogen research does, forcing questions about scientific responsibility in a warming world.
10. The reawakening of ancient viruses reframes our view of life’s persistence.
The ability of a virus to survive 30,000 or even 50,000 years changes the boundaries of what we consider alive. It challenges our assumptions about time, dormancy, and extinction itself. In a sense, the Earth is revealing its own biological memory, one capable of resurfacing when temperatures shift. The more we learn about these viral survivors, the clearer it becomes that climate change is not just melting ice, it’s melting history.